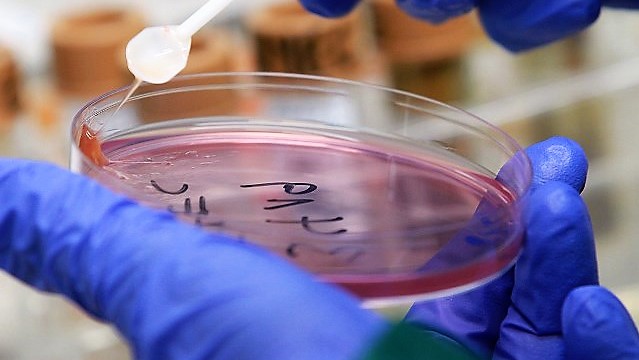

Последние данные об отравлении в Кизляре
Управление Роспотребнадзора по Республике Дагестан продолжает эпидемиологическое расследование по факту заболеваемости острыми кишечными инфекциями среди жителей г. Кизляра. Кроме того, оно сообщает и о количестве госпитализированных на этот час. Итак, за период с 6 по 17 января 2020 г. среди населения г. Кизляра зарегистрировано 124 случаев заболевания ОКИ, из которых 64 — приходится на детей до 17 лет.
По результатам лабораторных исследований материала от больных, выделены бактерии рода шигеллы (дизентерия). По предварительным данным эпидрасследования предполагаемым фактором передачи инфекции явилась загрязненная питьевая вода, подаваемая населению с грубыми нарушениями санитарного законодательства.
Из отобранных 10 проб водопроводной воды (от 13.01.2020г.) из эпидочагов – ни одна не отвечает гигиеническим требованиям по микробиологическим и санитарно-химическим показателям. Установлены факты неэффективного обеззараживания питьевой воды, подаваемой населению г. Кизляра. Водонасосные станции не оборудованы локальными установками по водоподготовке и обеззараживанию воды. Хлорирование проводится примитивным способом непосредственно в накопительных резервуарах чистой воды перед подачей в водопроводную сеть.
В целях локализации и ликвидации очага дизентерии Управлением Роспотребнадзора по РД организован полный комплекс профилактических и противоэпидемических мероприятий.
С 13 января, по Предписанию Управления Роспотребнадзора по РД прекращена подача воды с водонасосной станции №4 подаваемой централизованной системой водоснабжения в разводящую сеть г. Кизляр для питьевых и хозяйственно-бытовых нужд населению. Приняты меры по обеспечению населения питьевой водой, посредством ее подвоза на спецавтотранспорте. Усилен лабораторный контроль за качеством воды подаваемой населению г. Кизляра с ежедневным отбором проб воды, в т. ч. за соблюдением режима обеззараживания воды повышенными дозами хлора перед подачей в сеть на насосных станциях.
С целью активного выявления больных и установления медицинского наблюдения за контактными в течение 7 дней, Управлением даны Предписания ГБУ РД «ЦГБ г. Кизляра» о проведении подворных обходов, фагирования бактериофагом, а также экстренной иммунизации против гепатита А, брюшного тифа и дизентерии подлежащих контактов.
В адрес ОАО «Горводпровод» г. Кизляра вынесено Предписание о проведении комплекса профилактических мероприятий по ревизии, ремонту и дезинфекции всех водопроводных сетей и приведению качества питьевой воды в соответствие с установленными требованиями.
Главе МО «город Кизляр» с привлечением спецавтотранспорта АРС МЧС РД, так же направлено Предписание для проведения дезинфекции русла дренажной канавы и усиления контроля за санитарным состоянием территории. Дополнительно, руководителям предприятий общественного питания (48) даны Предписания о проведении санитарно-противоэпидемических мероприятий, в т. ч. о приостановлении своей деятельности до стабилизации эпидситуации, о проведении персоналом вакцинации против гепатита А и дизентерии Зонне, промывки и дезинфекции внутриплощадочных сетей водоснабжения и накопительных емкостей.
Среди населения Кизляра, усилена разъяснительная работа посредством распространения памяток и буклетов в ходе подворных обходов и привлеченных волонтеров общественных молодежных организаций. По факту регистрации случаев групповой заболеваемости ОКИ в Кизлярский межрайонный СО СУ СК России по РД направлено Постановление о возбуждении уголовного дела по ч.1 ст. 236 УК РФ.
Также, для принятия мер прокурорского реагирования в прокуратуру г. Кизляра направлена информация «О регистрации групповой заболеваемости ОКИ в г. Кизляре». Проведение противоэпидемических мероприятий и эпидемиологического расследования продолжается.
Ситуация остается на контроле Управления Роспотребнадзора по Республике Дагестан. Кроме того, Прокуратурой РД начата проверка по факту массового отравления граждан.
Профилактика
В период эпиднеблагополучия по острым кишечным инфекциям в г. Кизляре Управление Роспотребнадзора по РД рекомендует придерживаться несколько простых правил, которые помогут избежать кишечных заболеваний:
— не пейте сырую воду, употребляйте только кипяченую или бутилированную воду;
— мойте руки с мылом перед приемом пищи, после каждого посещения туалета, прогулок на улице;
— фрукты и овощи перед употреблением тщательно промойте проточной водой и обдайте кипятком;
— пища должна пройти достаточную термическую обработку, хранение ее должно осуществляться соблюдением соответствующих условий в холодильном оборудовании;
— по возможности избегайте употребления пищи, приготовленной на улице;
— не покупайте пищевые продукты, реализуемые на улице в неустановленных местах;
— соблюдайте чистоту в квартире и местах общего пользования, боритесь с мухами;
— соблюдайте правила гигиены при кормлении и уходе за детьми раннего возраста (обработка сосок, бутылок, правильное приготовление смеси и др.).
При любом желудочном — кишечном расстройстве, обращайтесь к врачу и подумайте о своем здоровье, о Ваших близких, о тех, кто может случайно оказаться с Вами и по Вашей вине заразиться.

Добавить комментарий